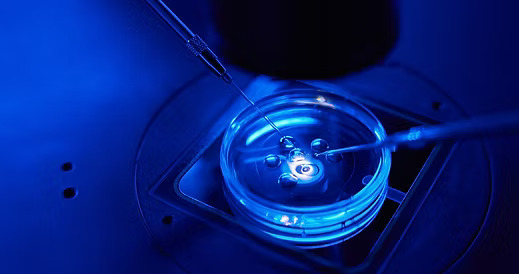

Intracytoplasmic Sperm Injection (ICSI)
ICSI: Precision Fertilization for Male Factor Infertility
ICSI (Intracytoplasmic Sperm Injection) is a highly advanced
form of In Vitro Fertilization (IVF) designed to overcome significant
challenges with sperm. This revolutionary technique involves the direct
injection of a single healthy sperm directly into a mature egg to achieve
fertilization. It is a powerful tool that has made parenthood possible for
countless individuals and couples facing male factor infertility.
How is ICSI Different from Conventional IVF?
Understanding the difference between conventional IVF and
ICSI is key:
- Conventional
IVF: In standard IVF, thousands of sperm are placed in a petri
dish near an egg, and one sperm must naturally swim to and fertilize the
egg on its own.
- ICSI: With
ICSI, our embryologists use sophisticated microscopic tools to select a
single, viable sperm and inject it directly into the center of the egg.
This bypasses many of the natural barriers to fertilization.
Think of it as the difference between inviting a group of
people to find their way to a destination versus providing a precise, guided
tour. ICSI offers that precision.
The ICSI Procedure: A Step-by-Step Guide
ICSI is performed in our embryology laboratory as part of an
IVF cycle. The steps are meticulous and require great skill:
- Egg
Retrieval: The process begins with the standard IVF step of
retrieving eggs from the ovaries.
- Sperm
Collection: A sperm sample is provided by the male partner or a
donor. In cases of severe male factor infertility, sperm may be surgically
retrieved from the epididymis (PESA) or testicles (TESA/TESE).
- Selection
and Immobilization: Under a high-powered microscope, an
embryologist carefully selects a single, morphologically normal sperm with
good motility. The sperm is gently immobilized to prevent damage to the
egg after injection.
- The
Injection: Using ultra-fine glass needles, the embryologist holds
the mature egg steady, punctures its outer layer (zona pellucida), and
injects the single sperm directly into the cytoplasm (the inner material)
of the egg.
- Monitoring
for Fertilization: The injected eggs are placed in an incubator
and checked the next day for signs of normal fertilization—the presence of
two pronuclei (one from the egg, one from the sperm).
When is ICSI Recommended?
Your fertility specialist may recommend ICSI for several
reasons:
- Severe
Male Factor Infertility: This is the most common reason,
including:
- Very
low sperm count (severe oligospermia)
- Poor
sperm motility (asthenospermia)
- Abnormal
sperm shape or morphology (teratospermia)
- Previous
IVF Failure: If previous IVF cycles resulted in failed or very
low fertilization.
- Surgical
Sperm Retrieval: When sperm is collected directly from the
testicles or epididymis (e.g., after a vasectomy, or due to an
obstruction).
- Unexplained
Infertility: In some cases of unexplained infertility, ICSI can
help ensure fertilization occurs.
- Preimplantation Genetic Testing (PGT): ICSI is often used with PGT to ensure that only the injected sperm’s DNA is tested, avoiding contamination from extra sperm that might be attached to the outside of the egg.
Success Rates and Considerations
ICSI is extremely successful at achieving fertilization,
with rates often exceeding 70-80% of mature eggs. However, it’s important to
understand that successful fertilization does not guarantee a pregnancy. The
resulting embryos must still develop normally and be capable of implanting in
the uterus to lead to a live birth.
The decision to use ICSI is made collaboratively between you
and your physician. While it is a powerful tool, it is not always necessary for
every IVF patient. Our team will recommend it based on a thorough review of
your medical history and specific fertility diagnosis.
Our Expertise in ICSI
The success of ICSI depends entirely on the skill and
experience of the embryology team. Our laboratory is staffed by highly trained
embryologists who are experts in this delicate micromanipulation technique.
They use the latest technology to ensure the highest standards of care for your
eggs, sperm, and embryos.
Have Questions About ICSI?
If you have been diagnosed with male factor infertility or
have experienced failed fertilization in the past, ICSI may be the solution
you’ve been looking for.
Contact us today to speak with a fertility specialist and
learn if ICSI is the right choice for your treatment plan.